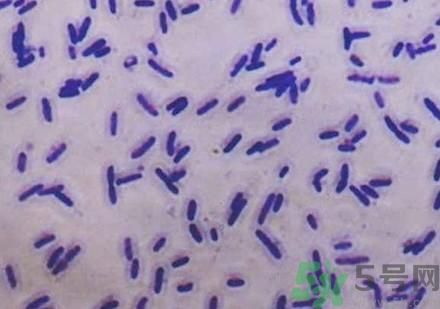
超級細(xì)菌感染后有什么癥狀?怎么預(yù)防超級細(xì)菌感染? 超級細(xì)菌感染后有什么癥狀?怎么預(yù)防超級細(xì)菌感染?

歡迎您,來(lái)到5號(hào)網(wǎng)!
當(dāng)前位置:首頁(yè) > 醫(yī)療 > 看病
時(shí)間:2016-05-30 08:49:09 編輯:本站整理 983
近日美國(guó)防部公布發(fā)現(xiàn)首例超級(jí)細(xì)菌,人感染病菌后的致死率達(dá)到60%,那么超級(jí)細(xì)菌感染后有什么癥狀?怎么預(yù)防超級(jí)細(xì)菌感染?
超級(jí)細(xì)菌,是指那些由于長(zhǎng)期被濫用抗生素的病人體內(nèi)產(chǎn)生的超級(jí)抗藥性的細(xì)菌,近年來(lái)陸續(xù)發(fā)現(xiàn)的超級(jí)細(xì)菌(Superbug)有:在美國(guó)發(fā)現(xiàn)的抗藥性金黃色葡萄球菌(MRSA)可以抵抗最強(qiáng)力的抗生素和藥物,并能夠引起各種感染;在法國(guó)發(fā)現(xiàn)的耐萬(wàn)古霉素腸球菌(VRE),因突破了人類(lèi)當(dāng)前對(duì)付細(xì)菌感染的“最后堡壘”——萬(wàn)古霉素防線(xiàn)而得名。這兩種細(xì)菌給人類(lèi)生命安全帶來(lái)的巨大威脅,是難以想象的:美國(guó)每年因“超級(jí)細(xì)菌”導(dǎo)致的死亡人數(shù)可達(dá)到18000例,超過(guò)了2005年美國(guó)死于艾滋病的16000人;在過(guò)去兩年內(nèi),法國(guó)已有313人發(fā)生VRE尿道或消化道感染,其中3人因無(wú)藥可治而死亡。
在日常的生活中,我們經(jīng)常說(shuō)消炎藥消炎藥,其實(shí)消炎藥就是抗生素也叫抗菌素,它的表現(xiàn)就是一旦出現(xiàn)了這種超級(jí)細(xì)菌的感染,它一般表現(xiàn)在像尿路感染,表現(xiàn)血流,肺部,傷口,而且這種感染是不太容易被控制的。比較危重癥的一些病人,他有一些炎癥的表現(xiàn),一般我們說(shuō)用抗菌素就應(yīng)該能夠消炎的了,包括一些由于細(xì)菌性的感染造成的一些肺部的炎癥,包括發(fā)熱等等,包括傷口的感染,如果我們用了一般情況我們用了抗生素。 就應(yīng)該是起作用了,但是如果感染的是超級(jí)細(xì)菌,這就很麻煩了,你用的抗生素,似乎就好像是你。這個(gè)細(xì)菌好像是你怎么打它,它都紋絲不動(dòng),包括它的發(fā)熱,包括傷口的感染沒(méi)有任何的這種好轉(zhuǎn),或者就說(shuō)根本就不能得到控制。

相關(guān)文章
熱門(mén)文章
積食發(fā)燒一般多少度?積食發(fā)燒和感冒發(fā)燒的區(qū)別
智齒拔完后有個(gè)洞怎么辦?拔智齒后有個(gè)洞多久能長(zhǎng)好?
安眠藥哪里可以買(mǎi)到?安眠藥藥店有賣(mài)嗎?
龍角散的服用方法 龍角散的功效與作用
積食發(fā)燒一般幾天能好?積食發(fā)燒一般持續(xù)多久?
去痰濕的中藥有哪些?去痰濕最好最快的方法
晚上睡覺(jué)把腳墊高好嗎 晚上睡覺(jué)腳放高有什么好處
骨盆前傾如何矯正 骨盆前傾矯正動(dòng)作圖解
花露水可以去螨蟲(chóng)嗎?花露水能去螨蟲(chóng)嗎?
女生下面長(zhǎng)白毛是怎么回事_陰道長(zhǎng)白毛怎么辦
女性左側(cè)小腹是什么器官?女性左側(cè)小腹痛是怎么回事?
女生體毛重能調(diào)理嗎?女生體毛重吃什么可以淡化?
5H跟帖
最熱標(biāo)簽
國(guó)家衛(wèi)健委疫苗接種遵循自愿原則 新冠疫苗接種查詢(xún)
安徽107歲老人主動(dòng)接種疫苗 新冠疫苗接種人數(shù)
0
中國(guó)新冠疫苗接種破14億劑次 新冠疫苗接種記錄查詢(xún)
廣西多地家屬未接種 學(xué)生暫緩入學(xué) 沒(méi)打新冠疫苗會(huì)不會(huì)影響出行
疫苗自愿接種原則不可廢 新冠疫苗自愿接種嗎
打新冠疫苗會(huì)增強(qiáng)免疫力嗎 孕婦打新冠疫苗會(huì)引起流產(chǎn)嗎
新冠疫苗會(huì)導(dǎo)致內(nèi)分泌失調(diào)嗎 打完新冠疫苗感覺(jué)呼吸困難怎么辦
新冠疫苗將來(lái)會(huì)收費(fèi)嗎 新冠疫苗滅活和重組哪個(gè)好
精選文章
猜你喜歡
網(wǎng)站簡(jiǎn)介|網(wǎng)絡(luò)營(yíng)銷(xiāo)|法律聲明|友情鏈接|聯(lián)系我們|意見(jiàn)反饋
Copyright ? 2012 - 2015 5h.com All Rights Reserved 5號(hào)健康網(wǎng)版權(quán)所有 鄂ICP備15005143號(hào)-3
提示:本站信息僅供參考,不能作為診斷及醫(yī)療的依據(jù);請(qǐng)謹(jǐn)慎參閱,本站不承擔(dān)由此引起的法律責(zé)任。本網(wǎng)站敬告網(wǎng)民:身體若有不適,請(qǐng)及時(shí)到醫(yī)院就診。
所有文章來(lái)自互聯(lián)網(wǎng) 如有異議 請(qǐng)與本站聯(lián)系 本站為非贏利性網(wǎng)站 不接受任何贊助和廣告
網(wǎng)友評(píng)論僅供其表達(dá)個(gè)人看法,并不表明5h立場(chǎng)。